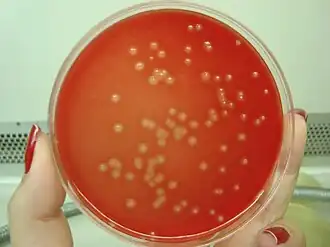

Streptococcus agalactiae
Streptococcus agalactiae
| |||||||||||||||
|---|---|---|---|---|---|---|---|---|---|---|---|---|---|---|---|
![]() | |||||||||||||||
| Classificação científica | |||||||||||||||
| |||||||||||||||
| Nome binomial | |||||||||||||||
| Streptococcus agalactiae ( Lehmann & Neumann 1896) | |||||||||||||||
Streptococcus agalactiae ou Streptococcus beta hemolítico são estreptococos do grupo B (SGB) é um diplococo gram-positivo encapsulado, anaeróbio facultativo, e quase todos produzem hemólise completa (β) em placas de ágar sangue. É reconhecido desde 1970 como o principal agente de infeção bacteriana perinatal.[1] Estas bactérias podem-se identificar como microorganismos colonizantes no tubo digestivo e aparato intestinal dos humanos e podem causar morte fetal intrauterina, trabalho de parto permaturo e corioamnionitis. No recém-nascido (RN) é responsável por infeção neonatal precoce (até aos 6 dias de vida) e, mais raramente, por infeção tardia (dos 7 aos 90 dias de vida)[2][3][4]. Estão ainda descritos casos de infeção em lactentes com mais de três meses de idade, habitualmente com histórico de imunodeficiência ou idade gestacional (IG) inferior a 28 semanas.[5][6]
S. agalactiae é o patógeno humano mais comum de estreptococos pertencentes ao grupo B da classificação de estreptococos de Rebecca Lancefield. Os GBS são circundados por uma cápsula bacteriana composta por polissacarídeos (exopolissacarídeos). A espécie é subclassificada em dez sorotipos (Ia, Ib, II–IX) dependendo da reatividade imunológica da sua cápsula polissacarídica.
Como características morfológicas apresentam as mesmas comuns ao gênero Streptococcus. Podem colonizar o trato genital feminino e são a principal fonte de infecção neonatal durante a gravidez e pós-parto, associada a taxas de mortalidade críticas em partos prematuros.[7]


Fatores de virulência
- Polissacarídeo capsular
- Ácido lipoteicóico
- Proteínas de superfície
- Hemolisina
- Enzimas
- Proteases, nucleases e hialuronidases
- Fator CAMP
- Nucleotideos
Fator CAMP
O Fator CAMP é considerado como fator de virulência devido a sua capacidade de se ligar a imunoglobulinas G e M, via fração Fc.Por outro lado, a detecção da produção do fator CAMP é de auxílio significativo na identificação de S. agalactiae.
Deve-se analisar em cultura realizada concomitante ao Staphylococcus aureus (de forma perpendicular) a formação de uma "seta" ou área de maior intensidade da Beta hemólise no local de interseção das amostras.
Doenças
- Endometrite
- Choque séptico
- Febre Puerperal
- Infecções no recém nascido, adquirida no útero / septicemia e meningite.
- Infecções tardias depois que o recém-nascido sai do hospital.
Diagnóstico Laboratorial
Gram Positivo disposto em pares e/ou cadeias; Catalase negativa Oxidase Negativa Presença de Beta Hemólise Ação do Fator CAMP e Antibiograma com identificação de resistência a Bacitracina.
Tratamento
- Penicilina (dose 12x maior que para S. pyogenes); penicilina + gentamicina ou outro aminoglicosídeo.
Prevenção
Obstetras tem usado administração parenteral de ampicilina intra-partum para prevenção quando suspeita-se da possibilidade de infecção. Estudos sobre vacinas em andamento.
Fasceíte necrotizante (raro)
Apesar de ser uma bactéria pouco virulenta normalmente, existem alguns casos (raros) de fasceíte necrosante de tecidos moles onde o Streptococcus agalactiae é isolado, quase sempre em pacientes imunocomprometidos (geralmente por diabetes mellitus 2). Inicialmente confunde-se os sinais como uma celulite, mas deve-se ter em atenção que a fasceíte necrotizante progride rapidamente, podendo levar a amputações, choque séptico ou mesmo morte.
Recomenda-se antibioterapia e debridamento o mais precocemente possível, tendo em atenção à área afectada, fazendo frequentemente a sua limpeza e drenagem, podendo mesmo ser necessário colocar enxertos no local do debridamento. [8][9][10][11]
Referências
- ↑ Baker CJ, Barrett FF. Transmission of group B streptococci among parturiente women and their neonates. J Pediatr 1973; 83:919.
- ↑ Phares CR, Lynfield R, Farley MM, et al. Epidemiology of invasive group B streptococcal disease in the United States, 1999-2005. JAMA 2008; 299:2056.
- ↑ Krohn MA, Hillier SL, Baker CJ. Maternal peripartum complications associated with vaginal group B streptococci colonization. J Infect Dis 1999; 179:1410.
- ↑ Eichenwald EC. Perinatally transmitted neonatal bacterial infections. Infect Dis Clin North Am 1997; 11:223
- ↑ Hussain SM, Luedtke GS, Baker CJ, et al. Invasive group B streptococcal disease in children beyond early infancy. Pediatr infect Dis J 1995; 14:278.
- ↑ Guilbert J, Levy C, Cohen R, et al. Late and ultra late onset Streptococcus B meningites: clinical and bacteriological data over 6 years in France. Acta Paediatr 2010; 99:47.
- ↑ «A first in-depth look at the microbiome of human sperm». Tech Explorist (em inglês). 3 de fevereiro de 2020. Consultado em 3 de fevereiro de 2020
- ↑ «Successful treatment of necrotizing fasciitis associated with diabetic nephropathy.»
- ↑ «An aggressive group a streptococcal cellulitis of the hand and forearm requiring surgical debridement.»
- ↑ «Report of 2 fatal cases of adult necrotizing fasciitis and toxic shock syndrome caused by Streptococcus agalactiae»
- ↑ «A rare case of diabetic hand ulcer caused by Streptococcus agalactiae.»